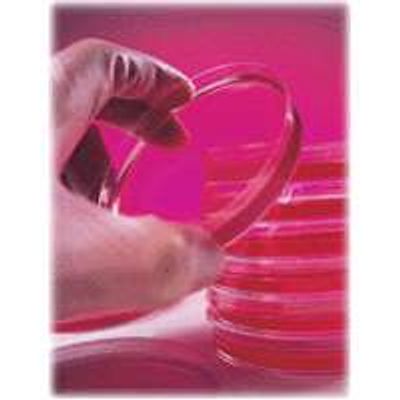

Mold Laboratory Services
Various microscopic techniques are employed to characterize molds. The available science recognizes a few different means of classifying molds. Traditional mycological methods rely on microscopy to differentiate genus and sometimes species of molds. Generally, these techniques are used to differentiate the spores released by the mature mold colonies growing on surfaces.
There are two major categories of mold analysis: viable and non-viable. Sometimes referred to as culturable and non-culturable, the analytical work for both categories rely on the identification of spores (or conidia) by light microscopy to classify the molds present.
Culturable samples may require additional identifying factors (i.e. associated hyphae and growth patterns of colonies on select culture media). The viable samples also require time (5-10 days) for cultures to mature enough where they can be accurately identified.
Though guidance documents exist, there are no accepted national standards or benchmark values to compare against to define exposure limits, accepted ambient levels or successful remediation clearance. IATL can supply useful information for the Mold Professional that may assist in the interpretation of analytical results. IATL also offers qualified customers discounts on sampling media through Enviropore.
- IATL uses only 1,000x magnification and oil immersion optics to qualify mold spores.
- IATL is proficient thru AIHA EMPAT.
- IATL technicians are all McCrone Research Institute trained for mold analysis.
- IATL`s history of customer service and integrity.

Non-Viable (Non-Culturable)
- Bioaerosols: Airborne Fungal Spore Identification
- Tape / Swab / Bulk: Direct Transfer Fungal Spore Identification
Viable (Culturable)
- Airborne Fungal Spore Identification (Anderson)
- Tape / Swab / Bulk: Direct Transfer Fungal Spore Identification after Growth on Selected Culture
